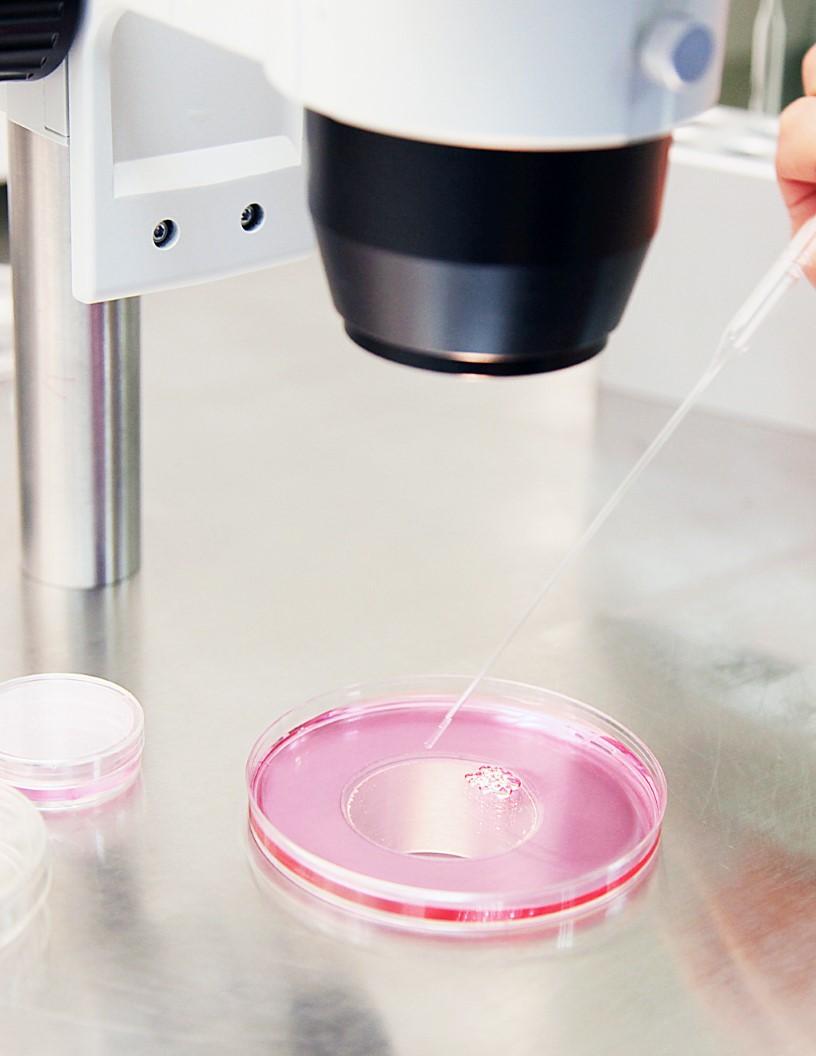
Sperm Separation Devices Market Analysis North America, Europe, Asia, Rest of World (ROW) - US, Germany, Japan, UK, China - Size and Forecast 2024-2028

Sperm Separation Devices Market Size 2024-2028
The sperm separation devices market size is forecast to increase by USD 27.20 th, at a CAGR of 8.9% between 2023 and 2028.
- The market is driven by the rising infertility rates and advancements in sperm separation technology. Infertility is a growing health concern worldwide, leading to an increasing demand for assisted reproductive technologies (ART). Sperm separation devices play a crucial role in ART, enabling the isolation and selection of high-quality sperm for fertilization. Advancements in sperm separation technology offer significant opportunities for market growth. Innovations in microfluidics, computer-assisted sperm selection, and magnetic-activated sperm sorting are enhancing the efficiency and accuracy of sperm separation processes. However, high costs associated with ART remain a significant challenge for both healthcare providers and patients.
- Affordability is a critical factor influencing the adoption of sperm separation devices, particularly in developing countries and among economically disadvantaged populations. To capitalize on market opportunities, companies must focus on developing cost-effective solutions while maintaining high-quality standards. Collaborations with healthcare providers and insurance companies could help reduce the financial burden on patients, expanding the reach of sperm separation devices and ART. Additionally, continuous research and development efforts to improve the accuracy and efficiency of sperm separation technologies will be essential to meet the evolving needs of the market.
What will be the Size of the Sperm Separation Devices Market during the forecast period?
Explore in-depth regional segment analysis with market size data - historical 2018-2022 and forecasts 2024-2028 - in the full report.
Request Free Sample
The market continues to evolve, driven by advancements in assisted reproductive technology (ART) and the need for improved sperm selection criteria. Sperm motility analysis plays a crucial role in this process, with techniques such as swim-up and density gradient centrifugation enabling the isolation of highly motile sperm. The acrosome reaction assay is another essential tool, assessing sperm membrane integrity and readiness for fertilization. ART laboratories employ various protocols to evaluate sperm morphology and semen quality, identifying morphology abnormalities and ensuring optimal conditions for fertilization. Density gradient centrifugation and Percoll gradient separation are commonly used methods for sperm concentration measurement and separation.
Computer-aided sperm analysis and microscope-assisted selection further enhance the process, allowing for precise evaluation of sperm parameters such as motility, morphology, and velocity. Sperm apoptosis detection and DNA fragmentation analysis provide valuable insights into sperm health and viability. Oxidative stress markers and embryo development rate assessments contribute to the ongoing research and development in this field. Microfluidic sperm separation and sperm chromatin structure analysis offer innovative approaches to improve sperm selection and fertilization outcomes. The continuous unfolding of market activities and evolving patterns underscore the importance of these technologies in ART applications.
How is this Sperm Separation Devices Industry segmented?
The sperm separation devices industry research report provides comprehensive data (region-wise segment analysis), with forecasts and estimates in "USD thousand" for the period 2024-2028, as well as historical data from 2018-2022 for the following segments.
- Type
- Conventional devices
- Advanced devices
- End-user
- Fertility centers
- Hospitals and clinics
- Cryopreserve banks and diagnostic labs
- Geography
- North America
- US
- Europe
- Germany
- UK
- APAC
- China
- Japan
- Rest of World (ROW)
- North America
By Type Insights
The conventional devices segment is estimated to witness significant growth during the forecast period.
The market incorporates advanced technologies to enhance the process of isolating and preparing high-quality sperm for assisted reproductive technologies. Microscope-assisted selection and computer-aided sperm analysis are among the innovative techniques that improve sperm selection based on morphology, motility, and other criteria. Microscope-assisted selection uses a microscope to visually assess sperm morphology and motility, while computer-aided sperm analysis utilizes advanced imaging and analysis systems to evaluate sperm parameters. Sperm apoptosis detection and DNA fragmentation analysis are essential tests to assess sperm health and viability. These tests help identify sperm with damaged DNA, which may negatively impact fertilization and embryo development.
Sperm preparation protocols, such as capacitation assessment and acrosome reaction assay, optimize sperm function and readiness for fertilization. Microfluidic sperm separation and flow cytometry sorting are emerging technologies that offer precise and efficient sperm separation. Microfluidic sperm separation uses fluid dynamics to separate sperm based on size, shape, and density, while flow cytometry sorting utilizes laser technology to identify and isolate specific sperm based on specific markers. Semen quality assessment plays a crucial role in the success of assisted reproductive technologies. Semen density gradient, percoll gradient separation, and sperm concentration measurement are essential tests to evaluate semen quality and sperm concentration.
Sperm chromatin structure and viability testing are also essential to assess sperm health and functionality. Intracytoplasmic sperm injection (ICSI) and testicular sperm extraction are advanced reproductive technologies that require high-quality sperm for successful fertilization. These procedures have led to an increased demand for advanced sperm separation techniques to ensure the best possible sperm selection and preparation. Oxidative stress markers are essential indicators of sperm health and functionality. Elevated oxidative stress levels can negatively impact sperm motility, morphology, and fertilization potential. Therefore, assessing oxidative stress levels in sperm is crucial for optimizing sperm preparation and improving fertilization outcomes.
In conclusion, the market is continuously evolving to meet the growing demand for advanced sperm selection and preparation techniques. The market encompasses a range of technologies, from conventional methods like swim-up and density gradient centrifugation to innovative techniques like microscope-assisted selection, computer-aided sperm analysis, microfluidic sperm separation, and flow cytometry sorting. These technologies aim to improve sperm quality, enhance fertilization outcomes, and ultimately increase pregnancy success rates.
The Conventional devices segment was valued at USD 24,867.20 th in 2018 and showed a gradual increase during the forecast period.
Regional Analysis
North America is estimated to contribute 34% to the growth of the global market during the forecast period. Technavio's analysts have elaborately explained the regional trends and drivers that shape the market during the forecast period.
The North American market for sperm separation devices experiences continuous growth due to the declining fertility rates, particularly in the US. With the fertility rate reaching its lowest point in over a century in 2023, at 55.8 births per 1,000 women of reproductive age, the need for advanced assisted reproductive technology becomes increasingly crucial. Sperm membrane integrity, microscope-assisted selection, computer-aided sperm analysis, and sperm apoptosis detection are essential components of these technologies. Semen density gradient techniques, such as epididymal sperm retrieval and testicular sperm extraction, are employed to enhance sperm selection criteria. Sperm motility analysis, swim-up technique, and acrosome reaction assay contribute to the evaluation of semen quality and the detection of morphology abnormalities.
Laboratory protocols, including capacitation assessment and sperm preparation, are meticulously followed to optimize fertilization rates. Density gradient centrifugation, Percoll gradient separation, and CASA system parameters are employed to measure sperm concentration and assess DNA fragmentation. Flow cytometry sorting is used to isolate viable sperm, while oxidative stress markers and embryo development rate assessments help monitor sperm chromatin structure and overall sperm health. Microfluidic sperm separation and sperm viability testing are also integral parts of the process. Intracytoplasmic sperm injection (ICSI) is a common application of these devices, with a significant impact on pregnancy success rates. The market's evolution is driven by the constant pursuit of improving fertility outcomes and addressing the growing demand for advanced reproductive technologies.
Market Dynamics
Our researchers analyzed the data with 2023 as the base year, along with the key drivers, trends, and challenges. A holistic analysis of drivers will help companies refine their marketing strategies to gain a competitive advantage.
What are the key market drivers leading to the rise in the adoption of Sperm Separation Devices Industry?
- The escalating infertility issue serves as the primary catalyst for market growth.
- Infertility, a condition characterized by the inability to conceive after a year of unprotected intercourse, affects approximately 17.5% of the global adult population, or roughly one in six individuals. This issue, which can result in significant emotional distress, social stigma, and financial strain, underscores the importance of effective fertility treatments. The market is driven by the rising prevalence of infertility, which shows minimal variation across different income levels and geographies. These devices play a crucial role in assisted reproductive technology (ART) by ensuring the selection of high-quality sperm for fertilization.
- Technologies such as microscope-assisted sperm selection, computer-aided sperm analysis, and semen density gradient methods help improve the chances of a successful pregnancy. Additionally, epididymal sperm retrieval techniques offer alternatives for individuals with obstructive azoospermia or low sperm count. The need for accessible, high-quality fertility care continues to grow, making the market an essential sector in the healthcare industry.
What are the market trends shaping the Sperm Separation Devices Industry?
- Sperm separation technology is experiencing significant advancements, emerging as a notable market trend in the reproductive health industry. This technological progression offers new possibilities for assisted reproductive treatments.
- The market is experiencing notable progress, fueled by technological innovations that heighten the precision and effectiveness of male fertility evaluations. One such development is the Memphasys Felix Device, which has already facilitated 11 successful births in India in 2023. This device embodies the industry's transition towards automation and intuitive user interfaces. By integrating electrophoresis and size exclusion membranes, the Felix System proficiently separates sperm from raw semen, minimizing human intervention and potential errors. Automation is transforming the sperm separation process, making it more efficient and dependable. Automated systems diminish the reliance on manual procedures, thereby lessening the risk of human error and ensuring consistent results.
- Sperm motility analysis, swim-up technique, acrosome reaction assay, and semen quality assessment are crucial aspects of ART laboratory protocols. Morphology abnormalities can significantly impact fertility, making precise sperm morphology evaluation essential. Density gradient centrifugation is a widely used technique for separating sperm from semen based on their density. The integration of automation into these processes enhances their accuracy and reliability, ultimately contributing to improved clinical outcomes.
What challenges does the Sperm Separation Devices Industry face during its growth?
- The escalating costs of assisted reproductive technologies pose a significant challenge to the industry's growth trajectory.
- The global market for sperm separation devices faces a significant challenge due to the high cost of Assisted Reproductive Technologies (ART). In Vitro Fertilization (IVF), a common ART procedure, involves multiple stages, each requiring meticulous monitoring and specialized equipment. These stages include sperm and egg collection, stimulation, fertilization, incubation, embryo freezing, and transfer. The complexity and labor-intensive nature of these procedures contribute to their substantial cost. An average IVF cycle includes numerous consultations with doctors, diagnostic check-ups, hormonal therapies, and egg retrieval. Sperm separation devices, such as Percoll gradient separation and flow cytometry sorting, play a crucial role in the IVF process by improving sperm concentration measurement and DNA fragmentation analysis.
- CASA system parameters further enhance the accuracy and efficiency of these processes. Testicular sperm extraction is another application of sperm separation devices, essential for individuals with obstructive azoospermia. Despite the high success rates of these procedures, the significant costs make them inaccessible for many individuals.
Exclusive Customer Landscape
The sperm separation devices market forecasting report includes the adoption lifecycle of the market, covering from the innovator's stage to the laggard's stage. It focuses on adoption rates in different regions based on penetration. Furthermore, the sperm separation devices market report also includes key purchase criteria and drivers of price sensitivity to help companies evaluate and develop their market growth analysis strategies.
Customer Landscape
Key Companies & Market Insights
Companies are implementing various strategies, such as strategic alliances, sperm separation devices market forecast, partnerships, mergers and acquisitions, geographical expansion, and product/service launches, to enhance their presence in the industry.
ARQUIMEA Agrotech - The ISAS V1 sperm analysis system by the company is a cutting-edge Computer-Assisted Sperm Analysis tool, delivering precise and efficient sperm separation for improved reproductive processes.
The industry research and growth report includes detailed analyses of the competitive landscape of the market and information about key companies, including:
- ARQUIMEA Agrotech
- Eppendorf SE
- Esco Micro Pte Ltd.
- LensHooke
- Memphasys
- Sperm Processor Pvt Ltd
- VetMotl Inc.
- Vitrolife AB
Qualitative and quantitative analysis of companies has been conducted to help clients understand the wider business environment as well as the strengths and weaknesses of key industry players. Data is qualitatively analyzed to categorize companies as pure play, category-focused, industry-focused, and diversified; it is quantitatively analyzed to categorize companies as dominant, leading, strong, tentative, and weak.
Recent Development and News in Sperm Separation Devices Market
- In January 2024, Meritus Biotech, a leading player in the market, announced the launch of its innovative MicroSort Separation System, which uses flow cytometry technology to separate X and Y sperm for sex selection procedures. (Meritus Biotech Press Release)
- In March 2024, Thermo Fisher Scientific and CooperSurgical entered into a strategic partnership to integrate Thermo Fisher's sperm separation technology into CooperSurgical's fertility offerings, expanding their combined reach in the global assisted reproductive technology market. (Thermo Fisher Scientific Press Release)
- In May 2024, Orig3n, a biotech company specializing in genetic testing, raised USD 50 million in a Series C funding round to expand its product offerings and invest in research and development, including sperm separation technology for improved IVF outcomes. (Orig3n Press Release)
- In January 2025, the European Union approved the use of sperm separation devices for sex selection procedures, marking a significant regulatory milestone that is expected to boost market growth and increase access to these advanced reproductive technologies in Europe. (European Commission Press Release)
Research Analyst Overview
- The market is witnessing significant advancements in response to the growing demand for improved male infertility diagnostics. Clinical pregnancy rates and live birth rates are key performance indicators, driving the adoption of innovative sperm evaluation techniques. Sperm washing techniques, such as density gradient centrifugation and swim-up methods, ensure optimal sperm quality for fertility procedures. Sperm DNA integrity and viability are crucial parameters assessed through sperm functional assays, oxidative stress assays, and DNA damage assessment. Sperm thawing methods and cryopreservation protocols play a vital role in maintaining sperm quality during storage. Automated semen analysis, image analysis software, and microscopic sperm evaluation enable precise assessment of sperm morphology, motility, concentration, and acrosome integrity.
- Sperm selection methods, such as flow cytometry and magnetic activated cell sorting, enhance embryo transfer success by isolating viable and motile sperm. IVF laboratories employ various procedures, including sperm freezing, semen sample preparation, and apoptosis detection methods, to ensure optimal sperm quality and improve overall fertility treatment outcomes. Sperm motility, morphology, and concentration are essential semen analysis parameters that influence the success of infertility treatments. By addressing these factors, the market continues to evolve, providing valuable solutions for the growing number of individuals seeking to overcome male infertility challenges.
Dive into Technavio's robust research methodology, blending expert interviews, extensive data synthesis, and validated models for unparalleled Sperm Separation Devices Market insights. See full methodology.
|
Market Scope |
|
|
Report Coverage |
Details |
|
Page number |
180 |
|
Base year |
2023 |
|
Historic period |
2018-2022 |
|
Forecast period |
2024-2028 |
|
Growth momentum & CAGR |
Accelerate at a CAGR of 8.9% |
|
Market growth 2024-2028 |
USD 27.20 thousand |
|
Market structure |
Concentrated |
|
YoY growth 2023-2024(%) |
8.5 |
|
Key countries |
US, Germany, Japan, UK, and China |
|
Competitive landscape |
Leading Companies, Market Positioning of Companies, Competitive Strategies, and Industry Risks |
What are the Key Data Covered in this Sperm Separation Devices Market Research and Growth Report?
- CAGR of the Sperm Separation Devices industry during the forecast period
- Detailed information on factors that will drive the growth and forecasting between 2024 and 2028
- Precise estimation of the size of the market and its contribution of the industry in focus to the parent market
- Accurate predictions about upcoming growth and trends and changes in consumer behaviour
- Growth of the market across North America, Europe, Asia, and Rest of World (ROW)
- Thorough analysis of the market's competitive landscape and detailed information about companies
- Comprehensive analysis of factors that will challenge the sperm separation devices market growth of industry companies
We can help! Our analysts can customize this sperm separation devices market research report to meet your requirements.

RIA -
RIA - 
